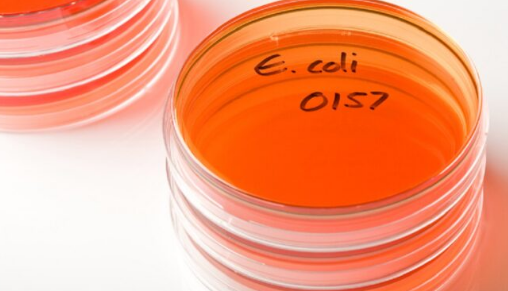
Shiga Toksini Üreten Escherichia coli (STEC) Enfeksiyonu, Bulaşma Yolları, Belirtileri ve Tedavisi

Escherichia coli ( E. coli ), gram-negatif, çomak ya da çubuk (basil) şeklinde bir bakteri grubudur. Normalde insan bağırsak (kolon) içeriğinde ve sıcakkanlı hayvanların bağırsaklarında yaşar, çok sayıdadır. Ayrıca, ister suda ister toprakta olsun, çevrede yaygın olarak bulunur. Gastrointestinal sistemin zararsız bir sakini olsa da aynı zamanda enterik hastalıklara ve idrar yolu enfeksiyonları (İYE) ve sepsis, menenjit gibi ekstraintestinal (bağırsak dışı ) hastalıklara neden olabilecek patojenik kapasiteye sahiptir.
E. coli’nin birçok farklı türü vardır. İki kategoride (intestinal ya da bağırsak içi ve ekstraintestinal yani bağırsak dışı patojenik E. coli) en az 11 farklı E. coli patotipi tanımlanmıştır. Bunların ayrımı hem bakteriyel genetiğe hem de spesifik izolatların konakçılarında meydana getirdiği patolojilere ve fenotiplere dayanmaktadır. E. coli’nin çoğu suşu (türü) zararsızdır, hiçbir hastalığa neden olmaz, ancak bazıları hafif hastalıklara neden olabilir. STEC gibi bazı patojen suşlar (türler ya da serotipler) güçlü toksinler üretebilir ve ciddi gıda kaynaklı hastalıklara neden olabilir. Shiga toksini üreten E. coli enfeksiyonuna STEC denir, ulusal sağlık hizmetlerine bildirilmesi ve takibi gereken bir hastalıktır. E. coli O157:H7 (Enterohemorajik E.coli serotipi =EHEC) halk sağlığı açısından en önemli ve dünya çapında en yaygın bir STEC serotipi ya da alt kümesidir. Salgınlar oluştuğunda sağlık yetkililerine bildirimi zorunludur. Ayrıca yüzlerce STEC serogrubu mevcuttur ve hepsi insan hastalığına neden olma potansiyeline sahiptir. Örneğin STEC 0104:H4 olarak da bilinen E. coli O104:H4 de ciddi hastalıklara ve salgınlara neden olabilir. E.coli 0157 nedeniyle oluşan enfeksiyonlara benzer olan bu serotip ender görülmektedir. Patojen serotipler arasında, 0157 ile ilişkili olmayan enfeksiyonlara neden olan E.coli 0121, E.coli 0104:H21, 0126, 0103, 045, 0145 ve 0111 gibi başka patotipler de bulunmaktadır.
Bu makalede STEC enfeksiyonu ve E.coli 0157, bulaşma yolları, belirtileri ve tedavi şekli ele alınmaktadır.
STEC ve E. coli O157
Shiga toksin (stx) ilk kez 1977’de tespit edilmiştir. Shiga toksini üreten E. coli (STEC) nispeten yeni tanınan patojenlerdir. İlk vakalar 1980’lerin başında görülmüş ve ilk sorunlar artık kötü şöhretli (en azından mikrobiyologlar arasında) bir serogrup olan E. coli O157:H7 (genellikle E. coli O157 olarak kısaltılır) üzerinde yoğunlaşmış, uygun şekilde pişirilmemiş hamburger gibi parçalanmış, kıyılmış sığır eti ürünleriyle bağlantılı olduğu anlaşılmıştır. O zamandan bu yana, O157 sadece çiğ/az pişmiş etlerle değil, inek ve keçi sütünden yapılan süt ve peynirler de dahil olmak üzere çeşitli süt ürünleriyle de ilişkilendirilmiştir.
1885’te Alman-Avusturyalı çocuk doktoru Theodor Escherich, Bacterium coli commune’ü çocukluk çağı ishalinin etkeni olarak tanımlamış ve birkaç on yıl sonra bakteriye resmi olarak keşfeden kişinin adı verilmiş ve Escherichia coli doğmuştur. İronik olarak, Dr. Escherich’in laboratuvarındaki orijinal suşun genom dizilimi, daha sonra aslında patojenite adaları ve Shiga toksini gibi iyi bilinen virülans faktörlerinden yoksun, bağırsak mikrobiyotasının iyi huylu bir üyesini izole ettiğini ortaya çıkarmıştır. Günümüzde E. coli, mikrobiyolojik, genetik ve moleküler biyoloji araştırmalarında en popüler model organizmadır ve tartışmasız bir şekilde gezegendeki en yoğun çalışılan ve en iyi anlaşılan organizmadır.

STEC Enfeksiyonu Nasıl Yayılır?
STEC’in ana kaynağı ot yiyen hayvanlar, özellikle ineklerdir ancak STEC ayrıca geyik, tavşan, at, domuz ve yabani kuşların da aralarında bulunduğu çeşitli hayvanların dışkısında da bulunmuştur. DSÖ tarafından 2019 yılında yayınlanan STEC hastalığına neden olan gıda kategorilerine ilişkin bir rapor, ABD’de izlenebilir vakaların %40’ının sığır etinden kaynaklandığını, Avrupa’da ise bu oranın %30 olduğunu göstermiştir. Her iki bölgede de sığır eti, diğer tüm gıda türlerinden daha fazla vakaya neden olmuştur. Gıda üretimi sırasında, uygun hijyen kurallarına uyulmadığı takdirde et, süt ve sebzeler STEC içeren hayvan dışkısı bulaşabilmektedir. STEC bir gıda içerisinde tüketilirse, bağırsağa ulaştıklarında çoğalmaya başlayacaktır. STEC için enfeksiyöz dozun çok düşük olduğu bilinmektedir. Sadece on hücrenin yutulmasının hastalığa neden olduğu düşünülmektedir. Belirtileriyle birlikte düşük enfektif doz, kişisel hijyene büyük özen gösterilmediği sürece hasta ve sağlıklı bireyler arasında kişiden kişiye yayılmayı mümkün kılmaktadır.
STEC enfeksiyonu insanlara kötü mezbaha hijyeni, dışkı materyalinin hazırlanmış karkaslarla temas etmesi de dahil olmak üzere çiğ veya az pişmiş kıyma gibi sığır eti ürünleri ve pastörizasyon işleminden geçmemiş, çiğ süt, bu sütlerden yapılan peynirler; elma şarabı, elma suyu gibi taze meyve suları; yıkanmamış çiğ meyve ve sebzeler dahil olmak üzere kontamine (kirlenmiş) gıdaların tüketilmesi; kontamine suyla ya da hasta kişilerle temas yoluyla yayılabilir. Kurabiye hamuru veya kek hamuru gibi çiğ hamurlar, marul, ıspanak, tere, lahana, filizlenmiş tohumlar ve fındık da dahil olmak üzere çiğ ürünler ve yapraklı yeşillikler, salatalar ile de bulaşabilir. Yeterince arıtılmamış su kaynaklarından su içmek, özellikle kırsal alanlarda gölet veya akarsu gibi kirli sularda veya yüzme havuzlarında yüzmek veya oynamak, duş almak, hasta insanlarla, özellikle de kusmuk veya dışkılarıyla, çiftliklerde enfekte hayvanlarıyla, evcil hayvan çiftliklerinde doğrudan, özellikle hayvan dışkısıyla yanlışlıkla temas da bulaşma yolları arasındadır. E. coli, enfeksiyonu olan diğer kişilerle (tuvaleti kullandıktan sonra, gıdaya dokunmadan önce yetersiz el hijyeni nedeniyle, özellikle evlerde, kreşlerde ve ana okullarında veya her ikisinde) temas durumunda insandan insana kolayca ve hızlı bir şekilde yayılır.
STEC’ler çok bulaşıcıdır çünkü hastalığa neden olmak için çok az sayıda bakteriye (muhtemelen 100’den az bireysel hücre) ihtiyaç vardır. Bu, hastalığın aileler içinde, küçük çocukların ve temiz kalmakta zorluk çekebilecek diğer kişilerin bulunduğu kreşler, ilkokullar, bakım evleri ve hastaneler gibi diğer ortamlarda kolayca yayılabileceği anlamına gelir. Enfekte yemekhane personelleri, gıda ürünlerini kirletme riski taşır ve enfeksiyonun yayılmasını önlemek için işten uzaklaştırılmalıdır.
STEC Enfeksiyonunun Belirtileri
Kanlı olabilen ishal (vakaların yaklaşık %50’sinde), karın ağrısı, şiddetli kramplar, bulantı ve kusma, hafif ateş STEC enfeksiyonunun belirtileridir. İnsanlar genellikle ağız yoluyla bakterileri aldıktan, enfekte olduktan 3 ila 4 gün sonra belirtileri fark ederler, belirtiler 1 ila 14 gün sonra herhangi bir zamanda da başlayabilir. Normalde ateş yoktur. Bazı kişilerde hafif ishal olabilir veya hiç belirti olmayabilir, buna asemptomatik taşıyıcılık denir. Komplikasyonsuz vakalarda belirtiler 2 haftaya kadar sürebilir. STEC her yaştan insanı etkilerken, çocuklar, yaşlılar ve bağışıklık sistemi zayıf olan kişiler ciddi hastalık açısından daha yüksek risk altındadır. Shiga toksin kana karışarak alyuvarlara (kırmızı kan hücreleri) zarar verir, anemiye ve böbrek yetmezliğine neden olabilir. Başta 5 yaş altı küçük çocuklar olmak üzere hastaların küçük bir kısmında (yaklaşık %8’inde), daha az idrara çıkma, dehidrasyon, yorgunluk, şişlik, morarma, sarı cilt ve gözler ile belirti veren, böbrek yetmezliğiyle sonuçlanabilen, yaşamı tehdit eden ciddi bir durum olan, kanama, nörolojik semptomlar (nöbetler) ile karakterize edilen hemolitik üremik sendrom (HÜS) adı verilen nadir fakat ciddi bir hastalık gelişebilir. HÜS’ün ölüm oranı %3-5 civarındadır. Yetişkinlerin küçük bir kısmında trombotik trombositopenik purpura (TTP) adı verilen benzer bir durum gelişebilir. Bu ciddi semptomlar genellikle hastaneye yatışla ve en kötü vakalarda ölümle sonuçlanır.
E.coli, idrar yolu enfeksiyonların da sebebidir. Bu durum idrar yaparken ağrıya veya yanma hissine neden olabilir. Bazen bir idrar yolu enfeksiyonu normalden daha sık idrara çıkma ihtiyacı hissedilmesine ve idrarda kana neden olabilir.
Seyahat ishali de E.coli kaynaklıdır. Dünya çapında seyahat (yolcu veya turist) ishali ve gıda zehirlenmesinin en yaygın nedeni E.coli’nin bir patotipi olan enterotoksijenik Escherichia coli (ETEC)’dir. ETEC enfeksiyonları, bir kişinin kontamine olmuş gıda veya suyu yutması halinde fekal-oral yolla bulaşmaktadır. Genellikle 5 ila 10 günden az süren ishal, karın ağrısı, bulantı ve kusmayla sonuçlanır. Az gelişmiş ülkelerin çoğunda endemiktir ve çocuklarda önemli ölüm oranlarına sahiptir.
E. coli’nin bazı suşları (türleri) pnömoni (zatürre veya akciğer iltihaplanması), yeni doğan bebeklerde menenjit, safra kesesi iltihabı (kolesistit) gibi ciddi olabilen hastalıklara da sebep olabilir.
STEC Enfeksiyonunun Tanısı
STEC enfeksiyonunun resmi tanısı genellikle dışkı (gaita) örneğinin laboratuar testine tabi tutulmasını gerektirir. Tahlil, E. coli bakterilerinin mevcut olup olmadığını, E. coli’den kaynaklanan toksinlerin veya zehirlerin mevcut olup olmadığını gösterir. Kan tahlili ile enfeksiyona karşı antikorlar kontrol edilir, hemolitik üremik sendrom ve sepsis olup olmadığı belirlenir. Tanıdan sonra doktor hastaya tavsiyede bulunur ve uygun tedavi sağlar, ayrıca bunu yerel halk sağlığı ekibine bildirir. Daha fazla bilgi ve enfeksiyonun daha fazla yayılmasını durdurmaya yardımcı olmak için hastayla iletişime geçilebilir.

Enfeksiyonun Yayılması Nasıl Engellenebilir?
Riskli yiyeceklerden kaçınarak ve iyi hijyen uygulayarak E. coli enfeksiyonu olasılığı azaltılabilir. Çiğ etler iyice pişirilerek tüketilmelidir. 2 dakikalık bir işlem sırasında 70 santigrat derecelik standart merkez pişirme sıcaklığı, altı log’luk önemli bir azalma (10 üssü 6 mikobakteriyi öldürme yeteneği) sağlayacaktır. Pastörize edilmemiş et ve sütten kaçınarak, çiğ ete dokunduktan ve hayvanlarla temas ettikten sonra, tuvaleti kullandıktan sonra (veya bebek bezi değiştirmek dahil başkalarına yardım ettikten sonra) yemek hazırlanması veya servisi öncesi eller iyice yıkanarak STEC enfeksiyonu önlenebilir. STEC’in şiddetli etkilerine özellikle duyarlı olan çocukların ve yaşlıların pastörize edilmemiş veya pişirilmemiş salam gibi et ürünleri yemesi önlenmelidir. Kullanımlar arasında iyice yıkanmadığı sürece, çiğ ve pişmiş gıdalara aynı aletlerle (maşa, bıçak ve kesme tahtası gibi) dokunulmamalıdır. Önceden hazırlanmamış ve üzerinde ‘tüketime hazır’ ibaresi bulunmuyorsa, salata yaprakları da dahil olmak üzere çiğ yenecek tüm sebzeler ve meyveler her zaman temiz suyla yıkanmalıdır fakat yıkamak kontaminasyonu (kirlenmeyi) ve enfeksiyon riskini azaltsa da enfeksiyon riskini tamamen ortadan kaldırmaz. Ayrıca, salata sebzeleri, çiğ et için de kullanılan kesme tahtası, bıçak gibi aletlerle hazırlanmamalıdır.
Kirlenmiş olabileceğinden doğrudan göllerden veya nehirlerden gelen arıtılmamış su içilmemeli, kaynağından emin olunmayan içme suyu kaynatılmalıdır. Yakındaki tarlalarda sığır ve koyunlar tarafından kirletilmiş olabileceği düşünülen suda yüzülmemelidir. Çiftlik ortamlarındayken yüzlere dokunmaktan veya parmakları ağızlara götürmekten kaçınılmalıdır. Çiftlik hayvanlarını öpülmemeli veya çocukların yüzlerini hayvanlara yaklaştırmasına izin verilmemelidir. Hayvanlara, çitlere veya hayvan alanlarındaki diğer yüzeylere dokunduktan sonra eller akan suda, katı sabun veya mümkünde sıvı sabun ve ılık suyla çok iyi yıkanmalıdır. Ellerini iyice yıkadıklarından emin olmak için çocuklar yakından denetlenmelidir. Elleri sabun ve suyla yıkamak yerine jel veya mendil kullanılmamalıdır çünkü ıslak mendiller E. coli O157’yi temizlememektedir. Hayvanlara dokunurken veya çiftlikte dolaşırken yemek yememeli veya herhangi bir şey içilmemeli, sadece piknik alanlarında veya kafelerde yiyip içilmelidir. Yemek yemeden veya bir şey içmeden önce eller sabun ve suyla iyice yıkanmalıdır. Kirlenmiş olabilecek botlar veya ayakkabılar çıkarılmalı ve temizlenmeli, bebek arabasının tekerlekleri temizlenmeli, ardından eller mutlaka sabun ve suyla yıkanmalıdır.
Başkalarının enfekte olmasını önlemek için sıkı hijyen önlemleri alınması çok önemlidir. Klozet koltukları, klozet sifon kolları, musluklar, lavabolar, yüzeyler ve kirlenmiş olabilecek kapı kolları gibi diğer alanlar en az her gün, tercihen daha sık deterjan ve sıcak suyla temizlenmeli, ev tipi dezenfektanla durulanmalıdır. Dezenfeksiyon spreyleri ve mendilleri veya alkol bazlı mendiller, klozetlerde ve diğer yüzeylerde ancak görünür kirler temizlendikten sonra kullanılabilir. Yoğun çamaşır suları (ağartıcılar) oldukça etkilidir, kirli yüzeyler için her 10 ölçek su 1 ölçek çamaşır suyu ile ve diğer sert yüzeyler için her 100 ölçek su bir ölçek çamaşır suyu ile seyreltilmelidir.
İdeal olarak, temizlik için dayanıklı ev tipi lastik eldivenler ve tek kullanımlık bezler kullanılmalıdır. Bezler plastik bir torbaya koyularak, ağzı kapatılarak ve evsel atıkların içine koyularak atılmalıdır. Lastik eldivenler kullanıldıktan sonra sıcak su ve deterjanla iyice yıkanmalı, ardından durulanmalı ve kurumaya bırakılmalıdır. Dışkı dökülmesi durumunda hemen müdahale edilmelidir. Kirlenmiş alan dayanıklı lastik eldivenler kullanılarak sıcak su ve deterjanla temizlenmeli, ardından eldivenler temizlenmeli ve eller iyice yıkanmalıdır. Havlular veya bebek bezi değiştirme matları (minderleri) paylaşılmamalı, kirli eşyalar mutfakta temizlenmemelidir.
Aileden birinde STEC enfeksiyonu varsa, tüm kirli kıyafetleri, ishal veya kusmukla kirlenmiş yatak takımları ve havluları diğer giysilerden ayrı olarak çamaşır makinesinde mümkün olan en sıcak yıkama programında (örneğin 60 santigrat derece) yıkanmalıdır. Çok kirli çamaşırlardan sonra çamaşır makinesinin dışı sıcak su ve deterjanla silinmelidir. Enfekte bir kişiyle temas ettikten, özellikle kıyafetlerine veya yatak takımlarına dokunduktan sonra da el temizliğine dikkat edilmelidir.
İşe veya Okula Dönüş
E. coli O157 enfeksiyonu geçiren herkes (çalışanlar, öğrenciler, çocuklar, gıda işleyicisi, çocuk bakıcısı veya sağlık çalışanı gibi), 48 saat boyunca semptomlardan (kusma ve ishal) tamamen kurtulana kadar iş, okul, kreş, anaokulu veya diğer kurumsal ortamlardan uzak durmalıdır. Çoğu kişi yaklaşık bir hafta sonra artık bulaşıcı değildir, ancak bazı kişiler, özellikle çocuklar, iyileştikten sonra birkaç ay boyunca E. coli O157 taşıyabilir. Bazı kişilerin işe veya okula dönmeden önce özel bakıma ihtiyacı vardır. Sağlık veya sosyal bakımda çalışılıyorsa veya yapılan iş yiyecekle uğraşmayı içeriyorsa, işe dönmenin ne zaman güvenli olduğu yerel yetkili çevre sağlık görevlilerine sorulmalıdır. Bu tavsiye hem enfekte olmuş kişiler hem de enfekte olmuş biriyle aynı evde yaşayan kişiler için geçerlidir. 5 yaşından küçük E. coli enfeksiyonu geçiren bir çocuk varsa veya enfekte olmuş biriyle yaşanıyorsa, çocuğun okula veya kreşe dönmesinin ne zaman güvenli olduğu aile hekimiyle konuşulmalıdır. E. coli O157 enfeksiyonu geçiren 5 yaş altı çocuklar, başkaları için enfeksiyon riski oluşturmadıklarını gösteren test sonuçları çıkana kadar halka açık yüzme havuzlarında yüzmemeli veya başkalarıyla aynı çocuk havuzunu paylaşmamalıdır.
Yiyeceklerin Hazırlanması ve Saklanması
Yiyecekleri güvenli bir şekilde hazırlamak, pişirmek ve saklamak önemlidir. Düşük sıcaklıklarda E.coli basillerinin büyümeleri önemli ölçüde engellenir. Bu nedenle buzdolaplarının düzgün çalıştığından emin olunmalıdır çünkü bakteriler 4 santigrat derecenin üzerindeki sıcaklıklarda daha hızlı büyür. Pişmiş yiyecekler, et ve süt ürünleri oda sıcaklığında yalnızca kısa bir süreliğine bırakılmalıdır. Tüketime hazır yiyeceklerin üzerine su damlamasını önlemek için pişmemiş, çiğ etler, pişmiş etlerin ve salata sebzelerinin altında saklanmalıdır. Pişmemiş ve pişmiş etler farklı tabaklarda saklanmalı, çiğ ve pişmiş etlerin her türlü temasından kaçınılmalıdır.
STEC’lerin asit dirençli olduğuna, çeşitli STEC suşlarının pH 4’te hayatta kalabildiğini gösteren çok sayıda yayın vardır ve pH’ı 3,6 kadar düşük olan gıdalar salgınlarda rol oynamıştır. Genel olarak, düşük bir pH, doğrulama yapılmadan STEC’i etkisiz hale getirmek için bir ölçüt olarak kullanılamaz. Taze ürünlerde en iyi kontroller hijyenik yetiştirme/hasat ve sulama sularının dikkatli kullanımıdır. Çapraz bulaşma, basit hijyen önlemleri kullanılarak kontrol edilebilir. Çapraz bulaşmadan kaynaklandığı tespit edilen salgınlara basit hijyen kontrolündeki bir aksaklık neden olmuştur.
O157 olmayan STEC organizmaları
O157 serogrubu hala birçok ülkede STEC ile ilişkili hastalıkların başlıca nedeni olsa da, ciddi salgınlara neden olan çok çeşitli başka serogrupların olduğu artık açıktır. Sonuç olarak, çeşitli ülkeler kirlenmiş (kontamine ) ürünleri test etmek ve satışını engellemek için önlemler almıştır. Örneğin, ABD’de STEC serogrupları O26, O45, O103, O111, O121 ve O157 için çeşitli sığır etlerinin test edilmesi yasal bir zorunluluktur, çünkü artık bunların hepsinin ciddi hastalıklara neden olduğu veya neden olma potansiyeline sahip olduğu kabul edilmektedir. AB’de filizlenmiş tohum üreticilerinin filizlenmeye yönelik tohumları veya filizlenmiş tohum sulama suyunu STEC serogrupları O157, O26, O103, O111, O145 ve O104:H4 açısından test etmeleri yasal bir zorunluluktur. Pozitif bulunan numuneler piyasaya sürülmeyebilir.
Ne Zaman Tıbbi Tavsiye Alınmalı?
Kişiler çok iyi hissetmiyorsa veya bağışıklık sistemi zayıfsa sağlık uzmanına görünmelidir. Yetişkinde veya bir çocukta kanlı ishal varsa, özellikle sık veya şiddetliyse, 7 günden uzun sürüyorsa, karında ya da rektumda şiddetli ağrı, kilo kaybı varsa, çok miktarda çok sulu ishal söz konusu ise, uyuşukluk, normalden az idrara çıkma ve baş dönmesi, sersemlik hissi gibi susuzluk belirtileri varsa aile hekimiyle görüşülmelidir. 12 aylıktan küçük bir çocuk varsa ve hasta olduğundan endişe ediliyorsa, 24 saatten uzun süredir ishalleri varsa, gözleri çökmüş durumdaysa ve uykulu görünüyorsa yine, öncelikle aile hekimiyle (veya pratisyen hekimle) iletişime geçilmelidir.
STEC Nasıl Tedavi Edilir?
STEC enfeksiyonu için özel bir tedavi yoktur. Enfekte olan kişilerin semptomları hafifletmeye yönelik bakımı genellikle evde yapılabilir. İshal dehidrasyona (susuzluğa) yol açabileceğinden bol miktarda sıvı içmek önemlidir. Antibiyotikler önerilmez ve HÜS gibi komplikasyonlara yakalanma riskini artırmaları muhtemeldir. Doktor tavsiye etmediği sürece toksine maruz kalma süresini uzatabileceği için kusma önleyici veya ishal önleyici ilaçlar alınmamalıdır. İshal varsa ve kişi çok hasta değilse bol miktarda sıvı içerek sıvı alımını sürdürmelidir. Eczaneden satın alınabilecek oral rehidrasyon solüsyonu içilebilir. Seyreltilmiş olarak (1 ölçü içecek 4 ölçü suyla, örneğin 50 ml içecek 200 ml suyla karıştırılarak) meyve suyu veya meşrubat içilebilir. Hastalık genellikle kendi kendini sınırlar ve çoğu kişi tedavi olmasa da 5-10 gün içinde kendiliğinden düzelir.
Özet
E. coli, bir bağırsak kommensali olarak zararsız varlığının yanı sıra insan hastalıklarının önemli bir nedenidir. E. coli’nin birçok farklı türü vardır. Başta sığırlar olmak üzere birçok hayvanın bağırsaklarında ve dışkılarında bulunan STEC (Shiga toksini üreten Escherichia coli ya da E.coli 0157) muhtemelen en güçlü patojenik E. Coli türüdür. Ulusal olarak bildirilmesi gereken STEC, sulu ve/veya kanlı ishal, hemolitik üremik sendrom (HÜS) ve hemorajik kolit (HC) gibi çeşitli bağırsak patolojilerinin etkenidir. Ayrıca bakteriyemi ve sepsis, menenjit ve idrar yolu enfeksiyonları (İYE) gibi bağırsak dışı hastalıklara da neden olur ve hem sağlık hizmetleriyle ilişkili hem de toplum kaynaklı invazif bakteriyel hastalıkların en yaygın nedenlerinden biridir. Bazı gruplar şiddetli E. coli hastalığı açısından daha yüksek risk altındadır. Bunlara küçük çocuklar ve yaşlılar, bağışıklığı zayıf kişiler dahildir. İnsanlar çiftlik hayvanlarıyla yakın temasta bulunarak, az pişmiş sığır eti, kıyma yiyerek, pastörize edilmemiş süt içerek, kontamine çiğ sebzeler ve lahanalar gibi kontamine gıdaların tüketerek veya kontamine suda yüzerek veya içerek STEC ile enfekte olabilir. Yetişkin bir bireyde veya bir çocukta kanlı ishal varsa bir doktorla iletişime geçilmeli ve acil bir randevu istenmeli veya 112 (acil çağrı) aranmalıdır.
Bakterinin dışkıda güvenilir bir şekilde bulunması ve (sıcakkanlı) bir konakçı dışındaki çeşitli ortamlarda varlığını sürdürebilme yeteneği, su kalitesi için dışkı indikatör bakterisi olarak uzun süredir kullanılmasına neden olmuştur. Gıdalarda genel E. coli’nin varlığı bir hijyen göstergesi olarak görülmelidir. Hiç olmaması istenir, bazı gıda türlerinde çok düşük bir seviye kabul edilebilir, ancak yüksek seviyeler hijyen konusunda acil bir iyileştirme gerektiğini gösterir. Gıda zincirlerinde güvenlik önlemleri olsa da iyi el hijyeni uygulamak ve gıda güvenliği tavsiyelerine uymak E. Coli’ye yakalanma şansı azaltılabilir. E. coli nedeniyle enfekte olan kişiler belirtiler ortadan kalktıktan, iyileştikten sonra en az 48 saat boyunca başkaları için yemek hazırlamamalıdır.
Yazar: Müşerref ÖZDAŞ
Benzer Yazılar
Yorumlar kapatılmıştır.





